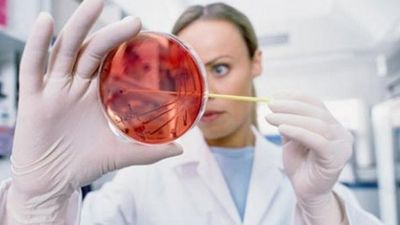
2016/03/349153.jpg

Kur hepatiti akut shndërrohet në kronik
Shkencëtarët pranë Qendër Helmholtz në Braunschweig demonstrojnë mënyrën se si reagon sistemi imun te një infeksion me hepatit B.Burimi: Helmholtz Association of German Research Centres
Për ta vërtetuar këtë, shkencëtarët kanë ekzaminuar incidencën dhe llojet e qelizave speciale mbrojtëse, qelizat T-Helper, së bashku me rolin e tyre në zhvillimin e sëmundjes. Me ndihmën e analizave gjenetike, ata kanë treguar se si gjenet në këto qeliza imune janë të rregulluar ndryshe në raport me zhvillimin e sëmundjes. Këto rezultate të reja mund t’iu ndihmojnë mjekëve për të zbuluar nëse një infeksion është i mjekueshëm, ose nëse pas vendosjes në mëlçi, ai do të zhvillohet në formën e tij kronike, transmeton Telegrafi.
Llogaritet se 300 deri në 420 milionë njerëz (5% deri 7% të popullatës botërore) në mbarë botën kanë infeksion kronik me hepatit B, ndërsa vendin e parë me këtë infeksion e mban India. Sa i përket zhvillimit të sëmundjes, ndërmjet hepatiti B akut dhe kronik është bërë një diferencim. Simptoma më e shpeshtë e një infeksioni akut është verdhëza. Te 5% e të infektuarve, sëmundja shndërrohet në kronike, që do të thotë se virusi mbetet në mëlçi.
Nëse nuk mjekohet, hepatiti B kronik mund të çojë në ndryshimet të cilat kanë pasoja të rënda, siç është zhvillimi i cirrozës hepatike dhe kancerit të mëlçisë. Deri më tani, shkencëtarët nuk kanë arritur që plotësisht ta kuptojnë rolin që luan sistemi imun në karakterizimin e një hepatiti B akut dhe kronik.
Faktori vendimtar për të arritur një reaksion të duhur imun, është mobilizimi i shpejtë i qelizave imune. Këto qeliza në mënyrë specifike sulmojnë qelizat e infektuara të mëlçisë, duke mos i dëmtuar indet tjera të mëlçisë gjatë këtij procesi. Nënllojet e qelizave T-helper luajnë një rol vendimtar në arritjen e baraspeshës së domosdoshme nëdërmjet mbrojtjes imunologjike dhe tolerancës: qelizave T-efektore dhe qelizave T-rregullatore. Derisa qelizat T-efektore e luftojnë infeksionin viral dhe i vrasin qelizat e infektuara të nikoqirit, qelizat T-rregullatore suprimojnë reaksionin imun dhe ndërpresin veprimin e qelizave T-efektore. Ato po ashtu pengojnë shkatërrimin e indeve.
Grupi i shkencëtarëve ndërkombëtarë kanë ekzaminuar mënyrën se si qelizat T-helper ndikojnë në zhvillimin e hepatitit B. Kështu, ata kanë marrë mostrat e gjakut nga pacientët indianë me hepatit B dhe kanë krahasuar nivelin e nënllojeve të qelizave T (qelizave T-efektore dhe qelizave T-rregullatore) dhe ndikimin e tyre në zhvillimin e sëmundjes, si edhe kanë analizuar gjenet të cilat janë përgjegjëse për këtë gjë.
Ekipet hulumtuese kanë arritur të tregojnë se te hepatiti B akut, qelizat T-efektore janë skajshmërisht aktive dhe shkatërrojnë qelizat e infektuara të nikoqirit. Ndërsa, qelizat T-rregullatore parandalojnë qelizat T-efektore të mos dëmtojnë indet e shëndosha të mëlçisë gjatë kësaj faze të infeksionit. Nga ana tjetër. Qelizat T-efektore janë shumë pak aktive te hepatiti B kronik, pasi që qelizat T-rregullatore parandalojnë reaksionin imun dhe në këtë mënyrë shtohet numri i viruseve të hepatiti B, të cilët kanë mundësi që të jetojnë në organ (mëlçi). Lufta e vazhdueshme ndërmjet sistemit imun kundër virusit çon deri te dëmtimi i ngadalshëm i indit të mëlçisë. /Telegrafi/